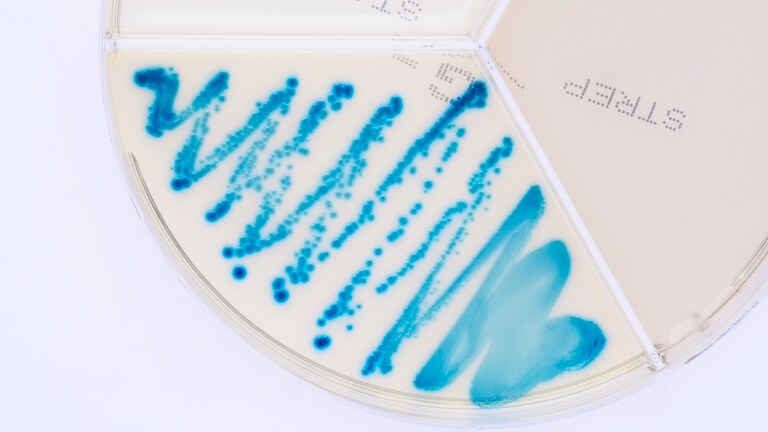
Klebsiella oxytoca ClearMilk Test

Klebsiella oxytoca is another bacterium from the Klebsiella genus which causes clinical mastitis. It is closely related to Klebsiella pneumoniae which is more common. Clinical and epidemiological connections and measures are identical for the both species mentioned.